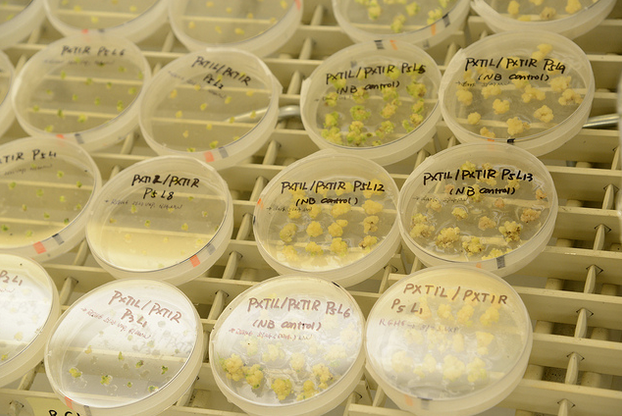

Investing in something shiny and new is quite alluring. It’s even more tempting when the potential for profit is not just enormous, but the investment can also literally save lives. That’s the attraction of biotechnology. However, you have to be careful to avoid being lured by a siren song when venturing into the risky biotech waters.
Even though the potential for profit is huge, there are many biotech startups that crash and burn. Never assume you’ve stumbled upon the proverbial pot of gold at the end of the rainbow. Instead, be cautious, and don’t be fooled by exaggerations meant to mislead you as an investor.
You also have to be aware that it could be a long wait before your investment comes to fruition. For example, it could take a decade to prepare a product application for FDA approval; then, it could take another year for the application itself to be reviewed.
If you have faith in the company you invest in, be patient and trust you will see a return on your investment. But at the same time, be smart; don’t overextend yourself. Know what you are able to risk.
Take the first steps.
Once you’ve found a biotech startup that interests you, it is time to look beyond the scientific jargon and amazing concepts. Will the startup you’re considering be a sound financial investment?
First, use your own logic to look beyond the scientific element and think about the reality. Don’t rely exclusively on the company’s scientific experts to help you understand the concepts.
Also, remember that seeing truly is believing. Instead of being enticed by scientific concepts and theory, keep in mind the reality of the results. It may sound futuristic and be backed by the scientific and academic communities, but if it lacks consistency in results, it can’t be applied in reality.
Is that biotech startup a good investment?
There are multiple aspects to consider with a biotech investment. These six signs will help guide you as you investigate a good biotech startup worth your investment:
- Exclusive technology: Be on the lookout for a startup with exclusive technology that is patented and copyrighted. If it is protected and is the intellectual property of the company, that’s a great sign.
- Diverse team: You want a team that is not only mindful in business, but also in academics. This will balance out the team’s understanding of reality; members should be both practical and conceptual, which will be important for maintaining a balance between fantastical and marketability.
- Low number of shareholders: How many shareholders own the company? The smaller the amount, the more room for you to own a more substantial percentage.
4. Straightforward product: When a startup has a noncomplex product, the technology can easily be transferred from the research stage to practical application. This will also help it get through the approval stage faster and move toward becoming a profitable product.
5. Pipeline potential: It’s a real treasure if a startup has a diverse technology pool that can eventually develop into multiple kinds of products, such as a drug, a medical device, a dietary supplement, a type of food, or even a line of cosmetics.
6. Digital assets: A good find is a company working on the digital end of the biotech industry, such as a database provider or biostatistical analytics. Those are always in demand so service providers will never run out of business.
Investing in a biotech startup can be a risky endeavor, but with good research, you will be on track to a rewarding adventure. Amazing results can be achieved when you take an informed risk. Digging into the pros and cons of the startup you are interested in is the first step in your biotech journey, but after you become well-informed, it won’t be the last.
Image credit: CC by: United Soybean Board